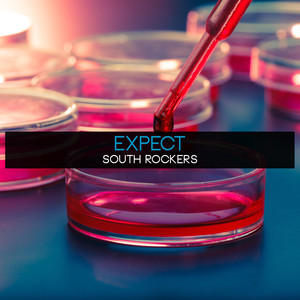
Circulation

Circulation
高木正勝

Circulation
乌鸦Producer

Circulation
Gray by Silver

Circulation
立山大
![Renai Circulation (English Cover) [TV Size]](https://p3.music.126.net/J75hiYxjsU2uam349Jil4g==/109951165233497648.jpg?param=300y300)
Renai Circulation (English Cover) [TV Size]
Lizz Robinett

Circulation (Uele Lamore Rework)
Eydís Evensen, Uele Lamore

Circulation
파란노을 (Parannoul)

Circulation
Dx Pasta

Circulation (feat. 里蘭花)
Mizuki Ohkawa, 里蘭花

Circulation(loop)
乌鸦Producer

Circulation
基诺

Circulation
Presence of Soul

Circulation(PUBG)
H3nry

Circulation
乌鸦Producer

Circulation
Sólveig Vaka Eyþórsdóttir, Pétur Björnsson, Guðbjartur Hákonarson, Hrafnhildur Marta Guðmundsdóttir, Birgir Steinn Theodorsson

Circulation
Clean Tears, 初音ミク

Circulation (Breeze Remix)
Clean Tears, 初音ミク

Circulation
Neko Hacker

Circulation (Album Version)
立山大

Circulation
Robert Fripp

CIRCULATION
ORIENTAL MAGNETIC YELLOW

Circulation
Clams

Circulation
馬場智章

Circulation
Robert Fripp

Circulation
Climatic

Circulation
みかん箱

Circulation
moumoon

Circulation
yamcha, 琴葉茜・葵

Circulation (Original Mix)
Freak

CIRCULATION
ZHI16
Circulation
Expect

Circulation
Deerhunter

Circulation
Amirtha Kidambi, Luke Stewart

Circulation (feat. 今泉正明, 生沼邦夫 & 大坂昌彦)
里見紀子, 今泉正明, 生沼邦夫, 大坂昌彦

Circulation
Lin Fu Chan

CIRCULATION
CW_505

Circulation (live)
King Crimson

Circulation
Ape On The Rocket

Circulation
CoralLoom

circulation
Antarctic Wastelands, Dear Gravity

Circulation
Yolabmi

circulation
Antarctic Wastelands, Dear Gravity

Circulation
Shamshir

Circulation
ISMAIL.M, Redspace

circulation
Beats Antique

Circulation
Mega 'Lo Mania

CIRCULATION
CIRCULATIONG

Circulation
Thurston Moore

Circulation
Laraaji

Circulation
Engage Blue

CIRCULATION
aoni

Circulation
Jacob Pavek

Circulation
Hotel Mira

Circulation
tender spring

Circulation
Masakatsu Takagi

circulation
刘四